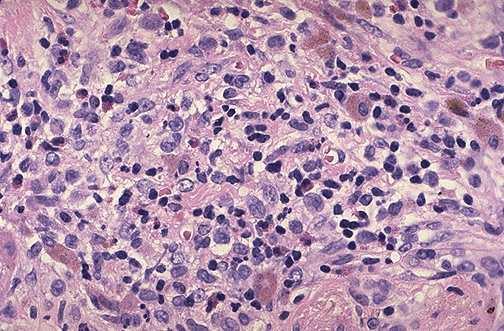

| At high magnification, the eosinophilic granuloma is composed of a mixture of inflammatory cells, with round to oval macrophages (which contain characteristic rod-shaped HX bodies by electron microscopy), lymphocytes, plasma cells, and even some eosinophils. |
![]() |